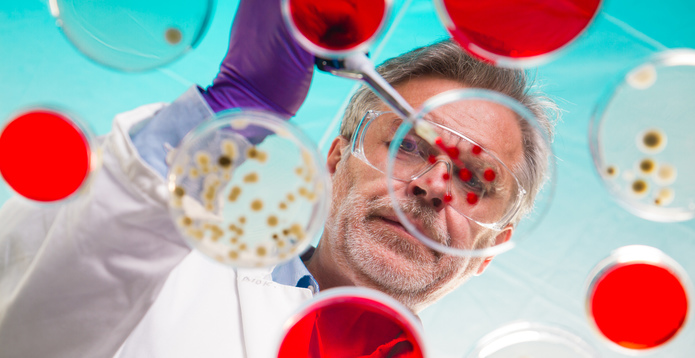
Life science researcher grafting bacteria

Out-Law News 3 min. read
Latest on R&D tax changes ‘reassuring’ to UK life sciences
01 Dec 2021, 10:33 am
Penny Simmons of Pinsent Masons was commenting after the UK Treasury published a new report into R&D tax reliefs (26-page / 332KB PDF), as part of its ongoing review in the R&D tax relief system.
The report confirmed that whilst territoriality restrictions will be introduced to refocus the ability to claim R&D tax reliefs towards R&D investment and innovation undertaken in the UK, companies will still be able to claim tax relief on the costs of software, data and cloud computing sourced overseas as well as payments for clinical trial volunteers overseas.
Simmons said: “The announcement that limited exclusions will be introduced to new territoriality restrictions on R&D tax relief claims will be reassuring to R&D intensive businesses”.
“Continuing to allow tax relief on payments made to overseas clinical trial volunteers will be particularly welcomed by the UK’s life sciences sector. There had been widespread concern across the sector, following the chancellor’s surprise announcement about territoriality restrictions in October’s Budget. Vital elements of UK life sciences R&D are often undertaken outside of the UK and can be essential to the development of the R&D itself. For example, to gain licensing approvals for new drugs or vaccines, clinical trials may need to be undertaken outside the UK,” she said
The new rules will be introduced from April 2023. The government will consult further on how the restrictions should be designed, with draft legislation expected to be published next summer for inclusion in next year’s Finance Bill, the report confirms.

Penny Simmons
Legal Director
There may be scope for further limited exceptions, since the government has said that it is interested in hearing views from stakeholders on this
“It is currently unclear how far the exceptions will go and as is often the case with tax changes, we are unlikely to gain clarity until draft legislation is published. There may be scope for further limited exceptions, since the government has said that it is interested in hearing views from stakeholders on this – so if businesses or stakeholders can justify an exception that is important to their R&D activities, won’t detract from the objective of encouraging UK focussed innovation and isn’t based on the fact that doing something overseas would be cheaper than in the UK, then they should be encouraged to engage with the Treasury,” said Simmons
Currently, there is no requirement that the R&D activity must be undertaken in the UK for companies to be eligible for R&D tax reliefs. UK companies that incur R&D expenses overseas may still be eligible for full tax relief. The government has said that it is introducing the restrictions to ensure that the reliefs incentivise UK innovation and are appropriately targeted in a way that best benefits UK industry.
Simmons said: “Until we have more details about how the restrictions and the exceptions will work, it is difficult to properly assess the likely impact on R&D intensive sectors, particularly UK life sciences. Given that the government appears to have responded constructively to comments received during the consultation, it is hoped that the final rules will include appropriate safeguards to ensure that the development of UK innovation and R&D is not unintentionally adversely affected.”
The report also details how the definition of R&D will be modernised and extended to include cloud computing and data costs. Two new categories of R&D expenditure will become eligible for relief: licence payments for data sets and cloud computing costs that can be attributed to computation, data processing and software. The government hopes the changes will “ensure the reliefs better incentivise cutting edge R&D methods which rely on vast quantities of data that are analysed and processed via the use of the cloud”.
“The importance of data and data processing when developing new technologies has become increasingly evident and this change will be well received,” said Simmons.
New measures to combat abuse of R&D tax reliefs were also confirmed. These include requiring all claims to be made digitally with endorsement by a named senior office of the company; requiring advance notice to HMRC before making a claim; and requiring greater detail about the claim, with details of any agents who advised the company on making the claim. The government hopes that these changes, once introduced, will tackle “abuse and boundary-pushing” in the system, without disadvantaging compliant businesses.
“Safeguarding the R&D tax reliefs system against abuse and fraud is vital,” said Simmons. “When designing the new measures, the Treasury will be faced with a careful balancing act to ensure they are effective, whilst not making the claims process overly complicated and inaccessible to small businesses and start-ups that may be reliant on the tax reliefs as a source of financing for UK innovation.”
The government opened a review into the R&D tax relief system in spring 2021. Details of the wide-ranging review were contained in a consultation paper that was published in March. Broadly, the scope of the review is to consider whether to expand the definition of R&D; continue to maintain two separate relief systems for larger and smaller businesses; introduce changes to how the system is administered; and introduce territoriality requirements to make the reliefs more targeted.
The report confirms that the review remains ongoing and has not concluded. The government will continue to consider other areas for reform, and will make further announcements as it does so.